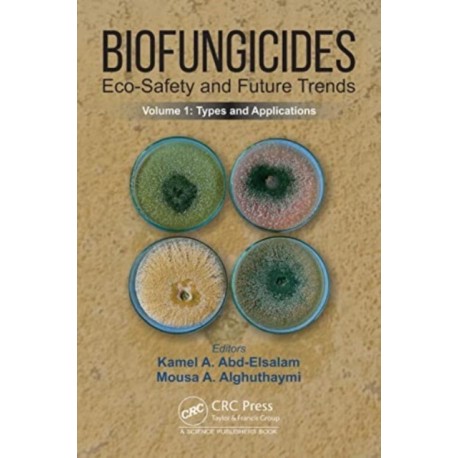

Kurv
Vare
varer
(tom)
Ingen varer
Fastlægges senere
Forsendelse
0,- kr
I alt
Biofungicides: Eco-Safety and Future Trends: Types and Applications, Volume 1
(Bog, Hardback, Engelsk)
Forlag:
Taylor & Francis Ltd
- Type: Bog
- Format: Hardback
-
Sprog:
Engelsk

- ISBN-13: 9781032262970
- Se flere detaljer ▼
Beskrivelse
The current volume focuses on all the major concerns associated with the biofungicides and provides comprehensive knowledge of microbial and phytochemical fungicides, bioformulations, regulation as well as limitation of biofungicides, and their role in disease management in plants.
Læsernes anmeldelser (0)
Alle detaljer
| Forlag | Taylor & Francis Ltd |
| Type | Bog |
| Format | Hardback |
| Sprog | Engelsk |
| Udgivelsesdato | 13-10-2023 |
| Første udgivelsesår | 2023 |
| Illustrationer | 26 Tables, black and white; 9 Line drawings, color; 16 Line drawings, black and white; 6 Halftones, color; 4 Halftones, black and white; 15 Illustrations, color; 20 Illustrations, black and white |
| Fagredaktør | Kamel A. Abd-Elsalam, Mousa A. Alghuthaymi |
| Originalsprog | United Kingdom |
| Sideantal | 316 |
| Indbinding | Hardback |
| Forlag | Taylor & Francis Ltd |
| Sideoplysninger | 316 pages, 26 Tables, black and white; 9 Line drawings, color; 16 Line drawings, black and white; 6 |
| Mål | 162 x 242 x 23 |
| ISBN-13 / EAN-13 | 9781032262970 |

